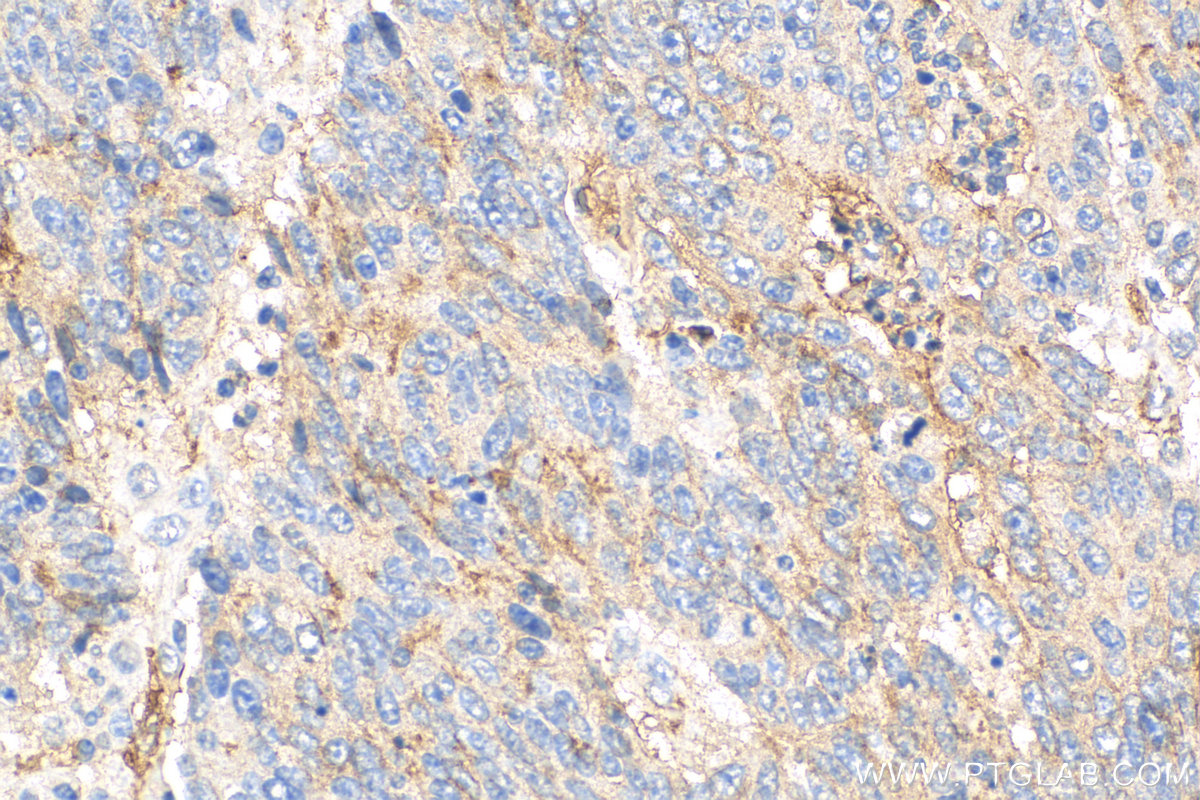

验证数据展示
经过测试的应用
| Positive WB detected in | A375 cells, human spleen tissue, K-562 cells, mouse brain tissue, HT-29 cells, HuH-7 cells, Jurkat cells |
| Positive IHC detected in | human lung cancer tissue, human stomach cancer tissue, human stomach tissue, mouse kidney tissue, human colon cancer tissue Note: suggested antigen retrieval with TE buffer pH 9.0; (*) Alternatively, antigen retrieval may be performed with citrate buffer pH 6.0 |
| Positive IF-P detected in | mouse small intestine tissue, human appendicitis tissue |
推荐稀释比
| 应用 | 推荐稀释比 |
|---|---|
| Western Blot (WB) | WB : 1:1000-1:3000 |
| Immunohistochemistry (IHC) | IHC : 1:250-1:1000 |
| Immunofluorescence (IF)-P | IF-P : 1:50-1:500 |
| It is recommended that this reagent should be titrated in each testing system to obtain optimal results. | |
| Sample-dependent, Check data in validation data gallery. | |
产品信息
12231-1-AP targets CD73 in WB, IHC, IF-P, ELISA applications and shows reactivity with human, mouse, rat samples.
| 经测试应用 | WB, IHC, IF-P, ELISA Application Description |
| 文献引用应用 | WB, IHC, IF, ELISA |
| 经测试反应性 | human, mouse, rat |
| 文献引用反应性 | human, mouse, rat, bovine |
| 免疫原 |
CatNo: Ag2869 Product name: Recombinant human NT5E,CD73 protein Source: e coli.-derived, PGEX-4T Tag: GST Domain: 32-264 aa of BC015940 Sequence: LHTNDVHSRLEQTSEDSSKCVNASRCMGGVARLFTKVQQIRRAEPNVLLLDAGDQYQGTIWFTVYKGAEVAHFMNALRYDAMALGNHEFDNGVEGLIEPLLKEAKFPILSANIKAKGPLASQISGLYLPYKVLPVGDEVVGIVGYTSKETPFLSNPGTNLVFEDEITALQPEVDKLKTLNVNKIIALGHSGFEMDKLIAQKVRGVDVVVGGHSNTFLYTGNCFKRIAWARMSR 种属同源性预测 |
| 宿主/亚型 | Rabbit / IgG |
| 抗体类别 | Polyclonal |
| 产品类型 | Antibody |
| 全称 | 5'-nucleotidase, ecto (CD73) |
| 别名 | NT5E, 5 NT, 5 nucleotidase, 5' nucleotidase, ecto (CD73), 5'-deoxynucleotidase |
| 计算分子量 | 29 kDa, 63 kDa |
| 观测分子量 | 60-70 kDa |
| GenBank蛋白编号 | BC015940 |
| 基因名称 | CD73 |
| Gene ID (NCBI) | 4907 |
| RRID | AB_2154081 |
| 偶联类型 | Unconjugated |
| 形式 | Liquid |
| 纯化方式 | Antigen affinity purification |
| UNIPROT ID | P21589 |
| 储存缓冲液 | PBS with 0.02% sodium azide and 50% glycerol, pH 7.3. |
| 储存条件 | Store at -20°C. Stable for one year after shipment. Aliquoting is unnecessary for -20oC storage. |
背景介绍
NT5E(5'-nucleotidase) is also named as NT5, NTE,CD73,ecto-5'-nucleotidase, and belongs to the 5'-nucleotidase family. It catalyzes the conversion at neutral pH of purine 5-prime mononucleotides to nucleosides, the preferred substrate being AMP.The enzyme occurs mainly as a dimer and the wide distribution of NT5E in the rat hippocampus, suggesting their involvement in the control of the purinergic signaling(PMID:17619139). This protein has two isoforms with the molecular weight of 63 kDa and 58 kDa and four glycosylation sites with a signalpeptide. It can exsit as a dimer(PMID:17619139). It can be detected the band of 55 kDa, 64 kDa, 70 kDa, 110 kDa by western blot(PMID:17619139; 12370277; 21533188). Defects in NT5E are the cause of calcification of joints and arteries (CALJA).
实验方案
| Product Specific Protocols | |
|---|---|
| IF protocol for CD73 antibody 12231-1-AP | Download protocol |
| IHC protocol for CD73 antibody 12231-1-AP | Download protocol |
| WB protocol for CD73 antibody 12231-1-AP | Download protocol |
| Standard Protocols | |
|---|---|
| Click here to view our Standard Protocols |
发表文章
| Species | Application | Title |
|---|---|---|
Adv Healthc Mater Dual-Barb Microneedle with JAK/STAT Inhibitor-Loaded Nanovesicles Encapsulation for Tendinopathy | ||
Int J Biol Sci CD73/NT5E-mediated ubiquitination of AURKA regulates alcohol-related liver fibrosis via modulating hepatic stellate cell senescence | ||
Br J Cancer Norepinephrine inhibits CD8+ T-cell infiltration and function, inducing anti-PD-1 mAb resistance in lung adenocarcinoma | ||
Theranostics GATA4-driven miR-206-3p signatures control orofacial bone development by regulating osteogenic and osteoclastic activity. | ||
Cell Mol Biol Lett Reciprocal negative feedback between Prrx1 and miR-140-3p regulates rapid chondrogenesis in the regenerating antler | ||
Theranostics A sericin/ graphene oxide composite scaffold as a biomimetic extracellular matrix for structural and functional repair of calvarial bone. |